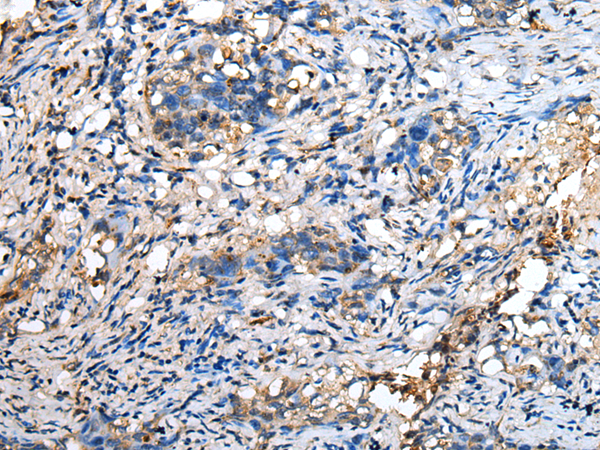
一抗

|
Background: |
This gene encodes a small glycolipid transport protein which acts as a substrate specific co-factor for the lysosomal enzyme beta-hexosaminidase A. Beta-hexosaminidase A, together with GM2 ganglioside activator, catalyzes the degradation of the ganglioside GM2, and other molecules containing terminal N-acetyl hexosamines. Mutations in this gene result in GM2-gangliosidosis type AB or the AB variant of Tay-Sachs disease. Alternative splicing results in multiple transcript variants. |
|
Applications: |
ELISA, WB, IHC |
|
Name of antibody: |
GM2A |
|
Immunogen: |
Fusion protein of human GM2A |
|
Full name: |
GM2 ganglioside activator |
|
Synonyms: |
SAP-3; GM2-AP |
|
SwissProt: |
P17900 |
|
ELISA Recommended dilution: |
5000-10000 |
|
IHC positive control: |
Human lung cancer |
|
IHC Recommend dilution: |
20-100 |
|
WB Predicted band size: |
21 kDa |
|
WB Positive control: |
Human 2-3 grade bladder transitional cell carcinoma tissue, Mouse kidney tissue, Hela cell, 293T cell, A375 cell |
|
WB Recommended dilution: |
200-1000 |


 購(gòu)物車(chē)
購(gòu)物車(chē) 幫助
幫助
 021-54845833/15800441009
021-54845833/15800441009